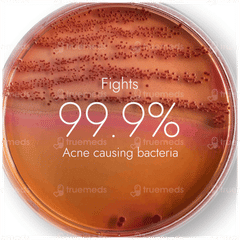
Kapiva Skin Rituals Acne Control Tulsi Face Wash 100ml

- Helps fight acne and dark spots.
- Helps reduce sebum secretion.
- Helps remove impurities from the skin's surface.
- Helps enhance skin tone.
- Helps brighten and hydrate skin.
- Helps provide naturally glowing skin.
Kapiva Skin Rituals Acne Control Tulsi Face Wash 100ml
Tube of 100 ML
MRP ₹299
₹254.15
₹2.99/ML
Use current location
Login to view saved addresses
100% genuine medicines
Safe & secure payments
15 days Easy returns
Product Highlights
Product Description of Kapiva Skin Rituals Acne Control Tulsi Face Wash 100ml
Kapiva Skin Rituals Acne Control Tulsi Face Wash is used for effectively reducing active acne and managing recurrence. This face wash is formulated with Panch Tulsi, Green Tea, and Neem to deeply cleanse and fight 99.9% of acne-causing bacteria. Panch Tulsi helps in targeting acne-causing bacteria, Green Tea’s antioxidant properties contribute to skin brightening and improved complexion, while Neem helps control excess oil production to keep acne in check. The natural herbal blend not only clears clogged pores but also helps remove impurities from both the surface and deeper layers of the skin. With consistent use, it may help enhance skin tone and hydrate the skin. Suitable for all skin types, it is free from parabens and sulphates, ensuring a pure, effective cleansing experience.
Ingredients of Kapiva Skin Rituals Acne Control Tulsi Face Wash 100ml
- Panch Tulsi: A blend of five types of Tulsi (Holy Basil) renowned for their potent antibacterial properties. Panch Tulsi helps to combat acne-causing bacteria effectively, reducing active acne and managing its recurrence. Its anti-inflammatory and antimicrobial properties support deep cleansing and promote a clearer complexion.
- Green Tea: Rich in antioxidants, Green Tea helps reduce inflammation and redness associated with acne. It contributes to skin brightening and improving overall skin tone by neutralising free radicals and enhancing complexion.
- Neem: Known for its natural antiseptic and antibacterial properties, Neem controls excess oil production, which is a key factor in acne development. It helps to soothe and calm the skin, reducing inflammation and reducing the chances of future breakouts. Neem’s ability to cleanse and purify the skin makes it an essential ingredient for managing acne.
- Other Ingredients: Aloevera Extract (Aloe barbadensis) 3ml, Triphala Extract (Terminalia chebula, Terminalia bellerica, Emblica officinalis) 2ml, Ginkgo Extract (Ginkgo biloba) 1ml, Lodhra Extract (Symplocos racemosa) 1ml, Van Tulsi Extract (Ocimum basilicum) 0.5ml, Arjak Tulsi Extract (Ocimum canum) 0.5ml, Rama Tulsi Extract (Ocimum gratissimum) 0.5ml, Nimbu Tulsi Extract (Ocimum citriodorum) 0.5ml, Centella Extract (Centella asiatica) Witch Hazel 0.5ml, (Hamameli virginiana)Extract 0.5ml, Willow Bark Extract (Salix alba) 0.5ml, Peony Extract (Paeonia officinalis) 0.2ml, Excipients: Sodium Lauroyl Sarcosinate 20.5ml, Cocamidopropyl Betaine 5.8ml, Vegetable Glycerin 2ml, Natural Moisturising Factor 1ml, Vitamin B3 1ml Natural Gum 1ml. Natural Chelating Agent 0.4mm, Natura Glucoside 0.4ml, Natural Symphytum officinale 0.3g, pH Adjuster, Natura Preservatives, Natural Thickene Natural Fragrance, Aqua Q.S..
Key Uses of Kapiva Skin Rituals Acne Control Tulsi Face Wash 100ml
- Helps Reduce Active Acne: The formulation effectively targets and reduces existing acne by combating acne-causing bacteria and clearing clogged pores.
- For Deep Cleansing: It thoroughly cleanses the skin, removing impurities and excess oil from both the surface and endodermis layers, ensuring a clearer and healthier complexion.
- Helps Control Acne Recurrence: The face wash helps reduce the chances of future breakouts by drying out active acne and controlling oil production, helping to maintain clear and acne-free skin.
- Helps Enhance Skin Tone: It helps brighten and even out skin tone with regular use, contributing to a glowing and refreshed appearance. It helps the skin to regain its natural complexion.
- Helps Hydrate and Soothe Skin: Provides a gentle yet effective cleanse, leaving the skin feeling hydrated and soothed, reducing redness and irritation associated with acne.
- Suitable for All Skin Types: Formulated to be effective yet gentle, making it suitable for all skin types, including sensitive skin. Free from parabens and sulphates for a natural cleansing experience.
How To Use
- Take a coin-sized amount and apply it to the wet face.
- Gently massage in a circular motion using your fingertips for better absorption.
- Rinse with water and pat dry.
Safety Information
- Read the label carefully before use.
- Keep out of the reach of children.
- Store in a cool, dry place away from direct sunlight and heat.
Disclaimer:
- This product is not intended to diagnose, treat, cure or prevent any disease.
- Discontinue use and consult your physician if you experience any side effects.
Additional Information
Good to Know
- It is a vegetarian product
- The face wash is free from parabens and sulphates
- Suitable for all skin types
- The product is non-GMO, GMP-certified and cruelty-free
Quick Tips
- For best results, apply the face wash morning and evening to maintain clear skin and manage breakouts.
- Wet your face with lukewarm water before applying the face wash to ensure better lather and effective cleansing.
Allergy Information
- Kapiva Acne Control Tulsi Face Wash contains natural herbal extracts such as Tulsi, which may cause allergic reactions in sensitive individuals. It also includes preservatives and surfactants like Sodium Lauroyl Sarcosinate and Cocamidopropyl Betaine. Perform a patch test before use to check for any adverse reactions.
Concerns It Can Help With
- Acne
- Skin Tone
- Excess Sebum Secretion
- Deep Cleansing
Frequently Asked Questions (FAQs)
What is Kapiva Acne Control Tulsi Face Wash used for?
Is it suitable for all skin types?
How often should I use this face wash?
Certified Content
Check out Editorial Policy
Manufacturer details
Country of origin: INDIA
Disclaimer
We, at Truemeds make a diligent attempt to deliver accurate, expert- drafted and thoroughly reviewed medicine related information to our consumers. However, it should, by no means, be considered a substitute for prescription from a certified doctor or a trustworthy doctor-patient relationship. In fact we detest any form of self medication without expert advice. The sole purpose of the information on our portal is to educate our consumers, which helps improve the communication between a doctor and a patient. The information by no means is complete in its entirety and should not be used to diagnose or treat any medical condition. No amount of information can replace the experience and expertise of a doctor, therefore his/her advice always holds priority and should be followed appropriately.
More Products By Adret Retail Pvt (Kapiva)


















Top-Selling Health Essentials
Health Articles
Top-Searched Medicines
...View more
Top-Selling Healthcare Devices
...View more
Company
About UsHealth ArticleHealth StoriesHealth LibraryDiseases & Health ConditionsAyurvedaUnderstanding Generic MedicinesAll MedicinesAll BrandsNeed HelpFAQSecuritySavings CalculatorSubscribe
Registered Office Address
Grievance Officer
Download Truemeds
Contact Us
Our customer representative team is available 7 days a week from 9 am - 9 pm.
v4.18.3
2026 - Truemeds | All rights reserved. Our content is for informational purposes only. See additional information.
Our Payment Partners